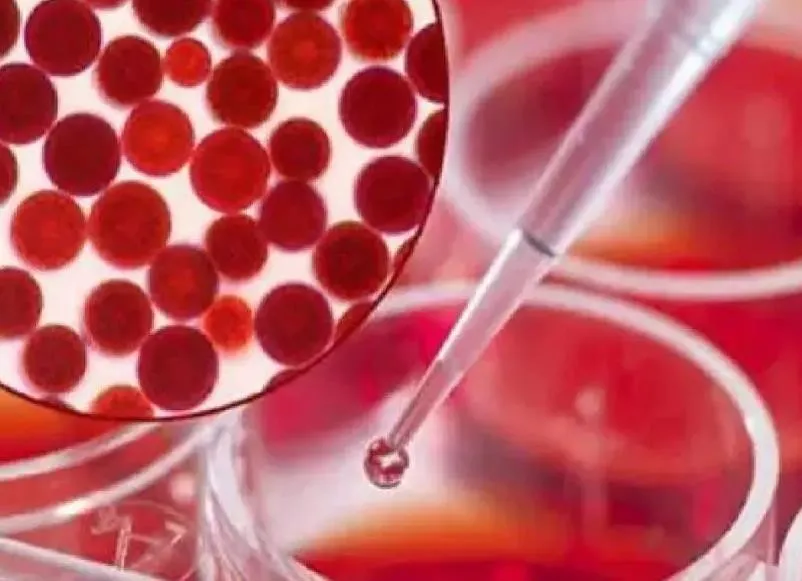

「叶黄素的功效与作用」总结(13点)
内容提要:【叶黄素的功效与作用】热度:9837
1、叶黄素的功效作用
| 1、抗氧化 |
| 2、抗突变 |
| 3、抗自由基 |
| 4、抗紫外线辐射 |

【1】抗氧化
叶黄素具有抗氧化的作用,可以减轻皮肤皱纹或者色素沉着的发生;
【2】抗突变
叶黄素具有抗突变的作用,可以预防肿瘤的发生,且具有抗癌作用;
【3】抗自由基
叶黄素可以抗自由基,有效清除使人体衰老的有害物质;
【4】抗紫外线辐射
叶黄素可抵抗紫外线辐射,眼睛的发育和保护离不了叶黄素。尤其是长期用眼的人群如学生、IT工作人员等,应该多补充叶黄素类的食品。
2、蓝莓叶黄素的功效

蓝莓叶黄素的功效与作用大多数是保护视力、抗氧化、抑制视网膜色素变性等,但是在吃的时候也需要经过专业医生的指导。
1、保护视力
蓝莓叶黄素摄入到体内之后,可以辅助增进视力,而且还具有改善夜盲症的效果,如果经常使用电脑的人可以适量吃。
2、抗氧化
蓝莓叶黄素也有不错的抗氧化效果,可以预防人体的衰老,还可以辅助清除体内的自由基。
3、抑制视网膜色素变性
蓝莓叶黄素能够增加视网膜的色素密度,在一定程度上可以改善视网膜变性,对于视网膜疾病恢复会有一定疗效。
3、叶黄素的副作用有哪些
叶黄素的副作用,主要是引起皮肤发黄、尿液发黄等。叶黄素是一种类胡萝卜素,在蔬菜、水果、花卉等植物中广泛存在,是人眼视网膜黄斑区的主要色素。叶黄素能够帮助眼睛的视网膜抵御外界的紫外线,对眼睛来说,叶黄素是一种重要的抗氧化剂。人体补充大量的叶黄素,有助于维护视力持久度,提高视觉反应时间,减少视觉伤害。对于近视者来说,补充叶黄素也可以延缓其近视度数的增加。
4、橘黄叶黄素的功效
| 抗氧化 | 防蓝光 | 抗疲劳 |

1、抗氧化
越橘叶黄素是含有了越橘提取物以及叶黄素等成分,对于保护眼睛和抗氧化能力比较好,因为在越橘提取物里面,含有了可以促进氧气和血液传输的作用,使眼部可以得到更多的营养,防止自由基伤害到眼部,毕竟眼部出现问题,大部分都是因为自由基的原因,所以越橘提取物里面的花青素,就是可以起到抗氧化剂的作用。
2、防蓝光
叶黄素主要是存在于蔬菜、水果以及花卉等植物中,而这种植物黄体素对眼视网膜黄斑区域十分有益处,平时菠菜、猕猴桃、甘蓝等,都含有了大量的叶黄素,属于优质的抗氧化剂,能起到抗氧化和阻蓝光的作用,所以叶黄素可以阻止蓝光对眼睛的伤害,使细胞不会受到自由基的损害,起到保护眼睛的作用。也就是说电子产品的蓝光伤害眼睛,而越橘叶黄素就可以起到过滤蓝光、抗氧化的功效。
3、抗疲劳
眼睛经常使用,就会出现疲劳现象,从而出现眼酸、眼胀以及流泪等现象,而越橘叶黄素可以起到保护眼睛外周循环和毛细血管的作用,不仅能让眼睛在暗处更能适应环境,还可以缓解眼睛疲营,是改善视疲劳比较好的一种产品。越橘叶黄素的作用与功效还是比较好的,而且平时保护眼睛也是十分重要的事情,特别是经常使用电子产品的人群以及视力易疲劳人群等,坚持每天服用两次、每次两粒紫一越橘叶黄素β-胡萝卜素软胶囊,可以达到过滤蓝光、抗氧化的功效。
5、奶粉添加叶黄素的功效与作用

叶黄素在奶粉里面主要是保护视力的,叶黄素是一种类胡萝卜素,它是人类视觉最敏锐部位-视网膜黄斑的重要成份之一,奶粉中的叶黄素是为了胎儿的视力发育。
6、虾青素和叶黄素一起吃有什么功效?
叶黄素可保护、缓解眼睛视网膜和黄斑部的问题;虾青素除了降低黄斑部伤害,也能减轻眼部疲劳、改善干眼问题。 我们可以想像叶黄素就是戴墨镜、帮眼睛挡光,虾青素则是帮眼睛打开水龙头,改善干涩、疲惫的问题,同时有抗发炎的效果。
7、叶黄素和虾青素的区别
叶黄素和虾青素的区别:
1、它们都是强大的抗氧化剂,虾青素的抗氧化功效是叶黄素的5-10倍,被称为超级维生素。
2、叶黄素保护和缓解眼睛视网膜和黄斑部的问题。虾青素降低黄斑部的伤害,缓解眼疲疲劳,改善干痒涩的问题。
3、叶黄素好像戴了墨镜,帮眼睛挡光和外部的各种伤害。
4、虾青素是帮眼睛打开自己的水龙头,改善干涩和疲惫。
8、越橘叶黄素的作用可以缓解眼睛干涩吗?
越橘叶黄素对眼睛干涩是有作用的,先来看看眼睛干涩的原因,主要由以下几点:
1、维生素A的缺乏,除眼睛干燥外,还有皮肤干燥或夜肓症表现。而叶黄素里面含有大量的维生素A。
2、常常看电脑、电视、瞬目的频率明显减少,泪膜蒸发的时间将会明显延长,引起眼睛干涩;
3、上了年纪的人,泪液分泌功能减退,出现眼睛干涩等,你这个初步看应该跟长时间面对电脑有关。
而越橘叶黄素则具有抗氧化剂和光保护作用,可促进视网膜细胞中的再生成,可预防重度近视及视网膜剥离,并可增进视力、保护视力。而且对缓解视疲劳有重大的作用。如果你也想吃些越橘叶黄素来护眼,可以试试健视佳叶黄素,除了叶黄素,更有花青素及胡萝卜素等护眼成分来帮你呢
9、儿童可以补充叶黄素吗
儿童可以适当的补充叶黄素,补充叶黄素可以提高人体内叶黄素的水平。利用叶黄素优质的抗氧化作用去除体内过多的氧自由基,从而恢复氧化、抗氧化系统的平衡,让身体保持健康,远离疾病。此外,叶黄素还存在于视网膜、黄斑区、玻璃体等正常眼组织当中,它是一种保护性的物质。因为叶黄素具有强抗氧化的作用,它能够吸收紫外线、蓝光等高能量的、对眼睛损害比较强大的光线,能够灭活玻璃体当中产生的氧自由基,提高玻璃体组织的抗氧化能力,防止玻璃体老化加剧,所以儿童可以适当的口服叶黄素,对人体是有好处的。
10、叶黄素能长期吃吗
叶黄素能长期吃。
1、叶黄素是从食物中提取,对人的身体有好处的,叶黄素对眼睛是有好处的,它是抗氧化剂,吃了之后可以预防近视度数的增加,有效减轻电子产品对眼睛的辐射伤害。对眼睛眼底和视网膜的功能有帮助。叶黄素的作用就相当于是给眼睛视网膜涂上了防晒霜,可以有效过滤有害射线对眼睛的伤害,缓解眼睛疲劳,所以长期服用叶黄素对视力有很积极的作用。
2、叶黄素的抗氧化作用还有美容养眼、延缓衰老的作用。很多食物也是富含叶黄素的,比如南瓜、菠菜等。所以也可以从食物中获取叶黄素,保持均衡多样的饮食习惯就可以保证日常需求。不是每个人都需要服用叶黄素,建议有需求的应该去正规渠道购买叶黄素,不要买假冒伪劣的产品,劣质叶黄素可能对人体有害。选择好的品牌和合适的剂量服用。
11、叶黄素哪个牌子好
| 1、GNC健安喜 |
| 2、Puritan's Pride普丽普莱 |
| 3、汤臣倍健 |
| 4、Doppelherz双心 |
| 5、BLACKMORES澳佳宝 |
| 6、CATALO家得路 |
| 7、自然之宝 |
| 8、HealthyCare |
| 9、来益健康 |
| 10、辉乐乐盯 |
1、GNC健安喜
品牌发源地:美国
健安喜创立于1935年,是闻名全球的美国营养品专业零售品牌,致力于为全球消费者提供安全优质的营养保健品,产品畅销全世界。
2、Puritan's Pride普丽普莱品牌发源地:美国
普丽普莱始于1973年美国,隶属于美国NBTY公司,公司专业从事各类营养健康食品的研发、生产和销售业务,已研发出超过1000种的营养品,销往世界各地。
3、汤臣倍健品牌发源地:中国
汤臣倍健创立于1995年,隶属于汤臣倍健股份有限公司,公司在全球23个国家拥有原料产地,采用最优质的原料,打造最令消费者放心的产品。
4、Doppelherz双心
品牌发源地:德国
双心始于1919年德国,是德国知名的天然营养食品品牌,也是螺旋藻十大品牌之一,在欧洲天然保健食品市场有着非常高的地位和影响力,销售网络遍布全球。
5、BLACKMORES澳佳宝品牌发源地:澳大利亚
澳佳宝始于1932年,是澳大利亚知名的保健品品牌,专注于为消费者提供安全、高品质的保健产品,产品品质深受全球消费者信赖。
6、CATALO家得路品牌发源地:美国
家得路是源自美国的天然健康食品品牌,品牌旗下拥有明眸护眼系列、强健骨骼系列、美肌抗老化系列等多种系列180多款天然健康产品,是消费者非常放心的品牌。
7、自然之宝
品牌发源地:美国
自然之宝始于1971年美国,隶属于美国NBTY公司,公司专业从事高品质营养补充剂的研发、生产和销售,销售网络遍及全球120多个国家。
8、HealthyCare品牌发源地:澳大利亚
HealthyCare成立于1989年澳洲,是Nature's Care 公司旗下高端保健保养品牌,公司生产的产品天然健康,远销欧美、亚洲等30多个国家。
9、来益健康品牌发源地:中国
来益健康是浙江医药旗下知名的叶黄素品牌,其叶黄素咀嚼片和天然维生素E软胶囊系列产品获得了众多消费者的肯定,在全国各地都很受欢迎。
10、辉乐乐盯品牌发源地:中国
辉乐乐盯是国内叶黄素行业知名品牌,隶属于广州市范乐医药科技有限公司,公司专业健康保健品的制造与销售,产品有着很高的市场占有率。
12、叶黄素真的能改善视力吗
一般来说,叶黄素不能改善视力。叶黄素又称为类胡萝卜素,是一种抗氧化剂。人类视网膜有一部位称为黄斑,是视力最敏锐的部位,同时有变色功能。黄斑区经过解剖发现局部富含叶黄素,因此适当补充叶黄素对于黄斑区有一定营养作用,所以叶黄素对眼睛有一定的好处。
13、含叶黄素的蔬菜和水果有哪些
叶黄素属于一种天然的活性类胡萝卜素,在日常生活中,较多常见的蔬菜和水果均含有一定量的叶黄素,如胡萝卜、西红柿、菠菜、韭菜、芹菜、香菜,以及芒果、猕猴桃、橙子、橘子等。叶黄素在人体黄斑区域内高浓度聚积,是视网膜黄斑的主要色素,增加自身叶黄素的摄入量,可以起到预防和改善老年性眼部退行性病变的作用,如视网膜色素变性、黄斑病变和白内障等。
相关内容
中国火车是国产吗?
一、中国火车是国产吗?,二、面粉添加剂都有啥,三、三聚磷酸钠属于哪种类型的化工产品啊,四、六偏磷酸钠是什么?,五、前几天安琪酵母公司做促销活动时送了我几包馒头改良剂,以前做馒头都没用过,不知这馒头改良剂有啥作用?,馒头改良剂,前几天,添加剂,钠是什么,改良剂,一、中国火车是国产吗?基本上都是国产。同其他产品一样,早期中国的铁路产品也是经历了万国造的阶段。但是中国人最令人佩服的就是自强不息。早期通过苏联的援助,我们以苏联的火车为蓝本制造出了东...
皇冠梨的功效与作用及禁忌
皇冠梨的功效与作用及禁忌,作用,预防,食欲,消肿,润肺,功效,梨的功效,心脏,功能效用皇冠梨是蔷薇目蔷薇科植物的一种,果实卵形或近球形,果核小,果肉洁白、质细腻,松脆多汁,果形周正,酸甜适口。具有预防心脑血管疾病、清心润肺、利尿消肿、增进食欲的功效。1.预防心脑血管疾病皇冠梨的营养价值丰富,适量食用可以保护心脏、减轻疲劳、降低血压,增强心肌活力,预防心脑血管疾病的发生。2.清心润肺皇冠梨性寒、味甘,具有清心润肺、祛痰止咳的功效,对肺结核、气...
苜蓿根的功效与作用及禁忌
苜蓿根的功效与作用及禁忌,苜蓿,烦满,热病,尿路结石,直立,草本,功效,功效与作用,苜蓿根,中药材。为豆科苜蓿属植物紫苜蓿MedicagosativaL.或南苜蓿MedicagohispidaGaertn.的根。紫苜蓿,分布于黄河中下游及西北地区;南苜蓿,分布于江苏、安徽、浙江、江西等地。具有清热利湿,通淋排石之功效。主治热病烦满,黄疸,尿路结石。性味归经苦,寒。入肝、肾经。形态特征1.南苜蓿,别名黄花草子、磨盘草子《中药大辞典》,苜齐头、...
皇冠梨的功效与作用及禁忌
皇冠梨的功效与作用及禁忌,作用,预防,食欲,消肿,润肺,功效,梨的功效,心脏,功能效用皇冠梨是蔷薇目蔷薇科植物的一种,果实卵形或近球形,果核小,果肉洁白、质细腻,松脆多汁,果形周正,酸甜适口。具有预防心脑血管疾病、清心润肺、利尿消肿、增进食欲的功效。1.预防心脑血管疾病皇冠梨的营养价值丰富,适量食用可以保护心脏、减轻疲劳、降低血压,增强心肌活力,预防心脑血管疾病的发生。2.清心润肺皇冠梨性寒、味甘,具有清心润肺、祛痰止咳的功效,对肺结核、气...
儿童泰诺的副作用(儿童泰诺的作用和功效)
1. 儿童泰诺的作用和功效,2. 儿童 泰诺退烧药作用,3. 儿童泰诺口服液,4. 泰诺儿童用药,5. 儿童泰诺的作用和功效有哪些,6. 儿童泰诺怎么服用,7. 儿童泰诺的作用和功效图片,儿童,作用,功效,副作用,儿童用药,1. 儿童泰诺的作用和功效小孩吃了泰诺没有退烧间隔两小时能喝美林,但是在服用前应当要首先阅读说明书,严格控制其服用的剂量。避免不良状况的产生。同时如果高温状态还没有缓解的话,应当可以使用物理的方法进行治疗。用冷水战士的毛...
卡达宾树皮的功效与作用(卡宾达树皮的功效用法的功效
1. 卡宾达树皮的功效用法的功效与作用,2. 卡宾达树皮的功效与作用和用法,3. 卡宾达树皮的功效用法用量,4. 卡宾达树皮的功效价格,5. 卡宾达树皮的功效与作用 使用方法,6. 卡宾达树皮功效和作用,7. 卡宾达树皮的功效与作用百科,功效与作用,功效,用量,使用方法,作用,1. 卡宾达树皮的功效用法的功效与作用在保证口感的情况下,卡宾达煲汤效果最好。卡宾达煲汤是一种常见的食用方式,因为卡宾达的特殊口感非常容易融入汤里,口感细腻,汤也会变...
葫芦瓜的营养作用与功效与作用(葫芦瓜的营养和功效)
1. 葫芦瓜的营养和功效,2. 葫芦瓜的营养和功效与作用,3. 葫芦瓜的营养功效与作用,4. 葫芦瓜的营养和功效与禁忌,5. 葫芦瓜的营养和功效作用,6. 葫芦瓜有什么营养价值也请读出来,7. 葫芦瓜的功效与作用及食用方法,8. 葫芦瓜的营养价值和功效,9. 葫芦瓜有什么营养和功效,10. 葫芦瓜的药用价值与功效,葫芦瓜,营养,功效,功效与作用,作用,1. 葫芦瓜的营养和功效葫瓜不是葫芦瓜,葫芦瓜一般指的是瓠子,葫芦瓜指的是葫芦科葫芦属一年...
黄金丝草图片及作用(黄金草有什么药用价值)
1. 黄金草有什么药用价值,2. 黄金草作用,3. 黄金草有什么药用价值呢,4. 黄金草治什么病,5. 黄金草的学名,6. 黄金草的药用价值和食用方法,7. 黄金草中药的别名,8. 中药黄金草的功能主治,9. 黄金草有什么作用,10. 黄金草是什么药,11. 黄金草介绍,药用价值,作用,中药,食用方法,草治,1. 黄金草有什么药用价值1.扦插繁殖:在黄金草的生长期,剪取它的枝条作为插穗,一般掐个头就好,长度在1-2厘米左右。这种植物的插穗很...
鹅油的营养与功效与作用(鹅油的营养与功效与作用是什
1. 鹅油的营养与功效与作用是什么,2. 鹅油的功效与营养价值,3. 鹅油的功效与应用范围,4. 鹅油的功效与作用百度百科,5. 鹅油的功效与作用及食用方法,6. 鹅油的营养与功效与作用是什么意思,7. 鹅油的功效与作用用途,8. 鹅油的营养与功效与作用是什么样的,9. 鹅油的营养与功效与作用是什么呢,10. 鹅油有什么功效,11. 鹅油的药用价值,鹅油,功效与作用,营养,功效,食用方法,1. 鹅油的营养与功效与作用是什么当然是经典的鹅油烤...
吃了开心果的副作用(吃了开心果会胖吗)
1. 吃了开心果会胖吗,2. 吃了开心果会胖吗女生,3. 吃了开心果会不会长胖,4. 吃了开心果会胖吗减肥,5. 吃开心果会胖吗每天吃多少不会胖,6. 吃开心果会长肥吗,7. 吃开心果会不会变胖,8. 吃开心果会发胖吗,9. 吃开心果会胖吗?,副作用,长胖,天吃,开心果,吃了,1. 吃了开心果会胖吗1、国外进口运费成本高首先,我们得知道这种水果其实不是国产的,它原产于叙利亚和伊朗等国家,因为它对于环境有一定的要求,必须要有很疏松的土质,气候...
吃了开心果的副作用(吃了开心果会胖吗)
1. 吃了开心果会胖吗,2. 吃了开心果会胖吗女生,3. 吃了开心果会不会长胖,4. 吃了开心果会胖吗减肥,5. 吃开心果会胖吗每天吃多少不会胖,6. 吃开心果会长肥吗,7. 吃开心果会不会变胖,8. 吃开心果会发胖吗,9. 吃开心果会胖吗?,副作用,长胖,天吃,开心果,吃了,1. 吃了开心果会胖吗1、国外进口运费成本高首先,我们得知道这种水果其实不是国产的,它原产于叙利亚和伊朗等国家,因为它对于环境有一定的要求,必须要有很疏松的土质,气候...
枇杷的核功效与作用及禁忌(枇杷核的性味归经)
1. 枇杷核的性味归经,2. 枇杷核能吃吗的功效与作用,3. 枇杷核的功能,4. 枇杷核是中药吗,5. 枇杷核有毒吗 枇杷核怎么吃不会中毒,6. 枇杷核能吃吗 枇杷核的功效与作用 - 搜狗问问,7. 枇杷核的药用价值,8. 枇杷核的功效与主治,9. 枇杷核的毒性,枇杷核,功效与作用,功效,能吃,性味,1. 枇杷核的性味归经枇杷核可以做成很多东西,下面介绍一些常见的用法:1. 茶叶将枇杷核晾干,去掉外面的皮,切碎后可以泡茶,具有清肺止咳、生津...
车厘子的作用与营养(车厘子功效和营养)
1. 车厘子功效和营养,2. 车厘子营养与功效,3. 车厘子功效和营养功效区别,4. 车厘子功效和营养价值,5. 车厘子有什么功效与营养,6. 车厘子的功效,7. 车厘子功效营养价值,8. 车厘子的营养及功效,9. 车厘子的功效和营养,10. 车厘子的营养价值与功效苹果绿,功效,营养,营养价值,作用,苹果绿,1. 车厘子功效和营养它营养价值高,坚持食用有很大的功效,车厘子具有促进消化、健脾和胃、美容养颜的作用。车厘子含有大量的营养物质,如花...
静脉注射一般用于什么作用(静脉注射的用途是什么)
1. 静脉注射的用途是什么,2. 静脉注射有什么药物,3. 静脉注射是什么?,4. 静脉注射百度百科,5. 静脉注射的用途是什么意思,6. 静脉注射百科,7. 静脉注射剂有哪些,药物,有哪些,作用,用途,有什么,1. 静脉注射的用途是什么静脉输液治疗,就是把药物通过静脉血管进入到体内,治疗疾病的方法。药物直接进入到血管,可以被人体组织快速吸收,起到快速治疗的作用。一般严重的疾病,或者不适用口服或者是肌注的药物,才可以输液治疗的。通过这个方法...
开塞露能起到什么作用(开塞露能起到什么作用和功效)
1. 开塞露能起到什么作用和功效,2. 开塞露有什么疗效,3. 开塞露有作用吗?,4. 开塞露能起什么作用?,5. 开塞露有何作用,6. 开塞露能起到什么作用和功效图片,7. 开塞露作用?,作用,露能,开塞,功效,疗效,1. 开塞露能起到什么作用和功效兰花油主要是用于给皮肤补水,以缓解皮肤干燥的症状,而开塞露其成分主要是水,也可以缓解皮肤的干燥症状,因此,兰花油和开塞露是可以一起使用的,而且这两者一起使用,对皮肤的补水功效也是很好的。开塞露...
旱芹菜有什么作用(旱芹是西芹吗)
1. 旱芹是西芹吗,2. 旱芹是芹菜吗,3. 旱芹水芹,4. 旱芹与西芹怎样区分,5. 旱芹是西芹吗图片,6. 旱芹菜能吃吗,7. 旱芹是什么样子图片,8. 旱芹是什么,9. 旱芹菜有毒吗,西芹,作用,芹菜,能吃,水芹,1. 旱芹是西芹吗毛芹菜和大芹菜都是芹菜科,属伞形科植物。有水芹、旱芹、西芹三种,功能相近,药用以旱芹为佳。旱芹香气较浓,称"药芹"。但是和香菜不是一个种,芹菜富含蛋白质、碳水化合物、胡萝卜素、B族维生素、钙、磷、铁、钠等。...
慈菇有什么作用及功效(慈菇的功效与作用及食用方法)
1. 慈菇的功效与作用及食用方法,2. 慈菇的功效和作用及食用方法,3. 慈菇的功效与作用及食用方法及禁忌,4. 慈菇的功效和副作用,5. 慈菇的功效与作用及食用方法禁忌,6. 慈菇的功效与作用什么人不能吃,7. 慈菇三种人不能吃,8. 慈菇的功效与作用及食用方法图片,9. 慈菇药用功效与作用,10. 慈菇的功效与作用及食用方法牛奶,慈菇,功效与作用,食用方法,作用,功效,1. 慈菇的功效与作用及食用方法可以吃,茨菇顶芽是茨菇的嫩芽,成分和...
儿茶酚胺正常范围及其作用(儿茶酚胺的组成成分及测定
1. 儿茶酚胺的组成成分及测定意义,2. 儿茶酚胺的测定意义是什么,3. 儿茶酚胺的组成成分及测定意义是什么,4. 儿茶酚胺的临床表现,5. 儿茶酚胺的生理学作用,6. 儿茶酚胺的临床意义,7. 儿茶酚胺包括哪些,8. 儿茶酚胺作用机理,成分,作用,生理学,意义,机理,1. 儿茶酚胺的组成成分及测定意义 儿茶酚胺是一种含有儿茶酚和胺基的神经类物质。儿茶酚和胺基通过L-酪氨酸在交感神经、肾上腺髓质和嗜铬细胞位置的酶化步骤结合。通常,...








